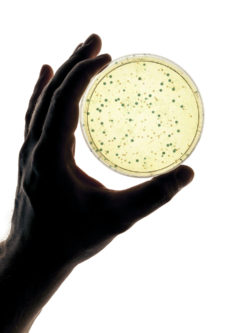
cardiac heater cooler infection

An ever-growing number of patients are coming forward, alleging that they have suffered from serious infections because of a contaminated heart surgery device. Plaintiffs allege that these infections are serious, and can even be life-threatening.
An ever-growing number of patients are coming forward, alleging that they have suffered from serious infections because of a contaminated heart surgery device. Plaintiffs allege that these infections are serious, and can even be life-threatening.
A growing number of heart surgery patients are reporting serious infections, allegedly due to contaminated heart surgery devices used during surgery. These infections can be serious and even life-threatening.
Contaminated Heart Surgery Devices
What are the heart surgery devices involved in these lawsuits? They’re commonly known as heater-cooler devices, and they’re manufactured by a number of companies. Heater-cooler devices are often used during heart surgeries, and are meant to regulate a patient’s blood and organ temperature. This warms and cools the blood as needed.
After undergoing heart surgeries, many patients have suffered from serious infections. They claim this is due to a contaminated heart surgery device used during their operation. While this is concerning in and of itself, it’s not just patients that are worried about the dangerous effects of contaminated heart surgery devices.
Indeed, the Center for Disease Control (CDC) has released a warning to consumers about the dangers associated with these devices. The warning notes that during the manufacturing process, some devices may have become contaminated. The CDC has warned that patients undergoing surgery with a contaminated heart surgery device may be at risk of developing serious infections, including nontuberculous mycobacterium (NTM).
The CDC has also said that the “overall risk of [mycobacterium] infection is low relative to other complications following surgery,” affecting between one in 100 and one in 1,000 patients. While the risk of developing an NTM infection from a contaminated heart surgery device is relatively slim, when it does occur, it may quickly become fatal.
Risk of Infection from a Contaminated Heart Surgery Device
Patients who have undergone surgery using a contaminated heart surgery device may be at risk of an NTM infection.
A nontuberculous mycobacterium (NTM) infection comes with several distinct symptoms. These symptoms include the following:
- Night sweats
- Aching muscles
- Joint pain
- Weight loss
- Fatigue
- Fever
Symptoms of an NTM infection may not appear immediately after the use of a contaminated heart surgery device. Instead, these symptoms may actually remain dormant for quite some time, even months after surgery and the initial infection to surface. This time can prevent patients from connecting the dots between the use of a contaminated heart surgery device and subsequent infection, leading to a delayed diagnosis of months or, in some cases, even years.
Filing a Contaminated Heart Surgery Device Lawsuit
If you or someone you love has suffered from an NTM infection after undergoing heart surgery with the use of a heart surgery device and believe that a contaminated heart surgery device may have been the cause, you may be able to file a surgical infection lawsuit. Filing a claim cannot take away the physical and emotional effects of such a serious infection, but it can help to compensate for the financial costs inevitably incurred by medical expenses and lost wages.
Do YOU have a legal claim? Fill out the form on this page now for a free, immediate, and confidential case evaluation. The cardiac heater-cooler attorneys who work with Top Class Actions will contact you if you qualify to let you know if an individual lawsuit or class action lawsuit is best for you. [In general, cardiac heater-cooler lawsuits are filed individually by each plaintiff and are not class actions.] Hurry — statutes of limitations may apply.
ATTORNEY ADVERTISING
Top Class Actions is a Proud Member of the American Bar Association
LEGAL INFORMATION IS NOT LEGAL ADVICE
Top Class Actions Legal Statement
©2008 – 2026 Top Class Actions® LLC
Various Trademarks held by their respective owners
This website is not intended for viewing or usage by European Union citizens.
Get Help – It’s Free
Join a Free Cardiac Heater-Cooler System Class Action Lawsuit Investigation
An attorney will contact you if you qualify to discuss the details of your potential case at no charge to you.
Please Note: If you want to participate in this investigation, it is imperative that you reply to the law firm if they call or email you. Failing to do so may result in you not getting signed up as a client, if you qualify, or getting you dropped as a client.
Email any problems with this form to [email protected].
Oops! We could not locate your form.












